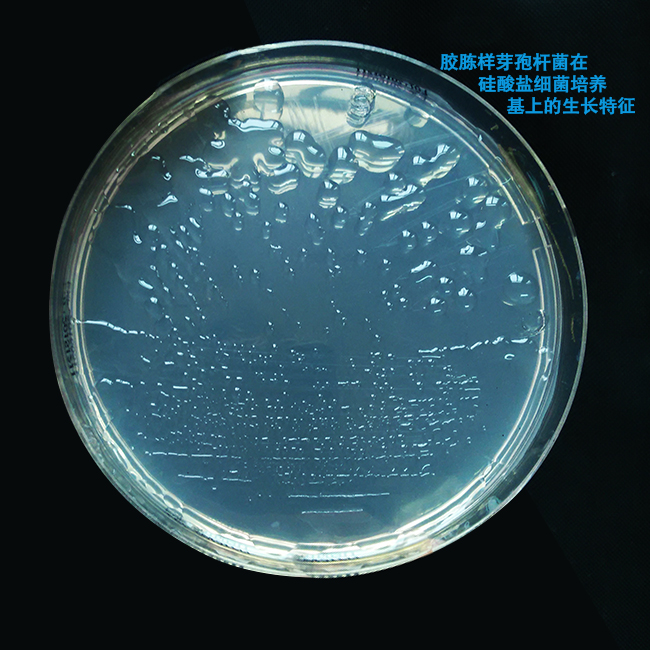
胶胨样芽孢杆菌在硅酸盐细菌培养基上的生长特征

用途:用于硅酸盐细菌的分离培养。
成分(g/L):
蔗糖
|
5.0
|
硫酸镁
|
0.5
|
碳酸钙
|
0.1
|
磷酸氢二钠
|
2.0
|
氯化铁
|
0.005
|
玻璃粉
|
1.0
|
琼脂
|
15.0
|
pH值7.0
|
25℃
|
用法
称取本品 23.6g,加热溶解于 1000ml 蒸馏水中,分装,121℃高压灭菌 15 分钟,备用。
注:培养基中的玻璃粉、硫酸镁、碳酸钙不溶,灭菌后有沉淀。
下图为胶胨样芽孢杆菌在硅酸盐细菌培养基上的生长特征:
硅酸盐细菌培养基(含琼脂)微生物灵敏度试验:
按标签用法制备培养基,接种以下质控菌株,放置28-30℃需氧培养48小时。

硅酸盐细菌培养基原理及实验现象:/asphtml/refere10142.htm


 海博微信公众号
海博微信公众号
 海博天猫旗舰店
海博天猫旗舰店


 海博微信公众号
海博微信公众号
 海博天猫旗舰店
海博天猫旗舰店






